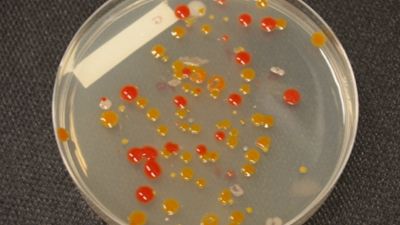
Bacterial isolates. The striking colours of are due to the protective pigments that shield the bacteria from strong radiation. - © A. Willems - UGent

Microbiologists Identify Sør Rondanes as Bacteria Hotbed
Scientists Karolien Peeters and Anne Willems from Ghent University and Damien Ertz from the National Botanic Garden of Belgium, who were down in Antarctica in January 2007, recently published a study in the journal Systematic and Applied Microbiology. The study focuses on the heterotrophic bacterial diversity (bacteria that depend on other organisms for their energy supply) present at the Sør Rondane site prior to the construction of the Princess Elisabeth Station.
For the study, the team of scientists collected approximately 800 bacterial isolates from two microbial mats after incubation. The team then grouped the bacteria they found thanks to PCR (Polymerase Chain Reaction) fingerprinting, a technique used to “amplify” specific parts of DNA. Next, characteristic DNA sequences (the 16S rRNA genes) were determined and compared to an existing shared database (EMBL database) for matches. Further gene sequence analyses allowed the team to classify the bacteria they found into five phyla:
• Actinobacteria
• Bacteriodetes
• Proteobacteria
• Firmicutes
• Deinococcus-thermus
The study was the first one ever to study bacteria in the Sør Rondane area, where the Princess Elisabeth Station was built, and was also one of the few to use bacterial cultures to study them. Antarctica is an isolated place, which implies that the organisms that survive there are under a high selection pressure. This study not only recovered a considerable number of new species and genera which possibly belong to local taxa, but it also identified the site as an important region for further investigation.
Picture: Bacterial isolates. The striking colours of are due to the protective pigments that shield the bacteria from strong radiation. - © A. Willems - UGent
